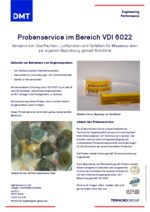
Probenservice VDI 6022

Hygieneinspektionen von RLT-Anlagen nach VDI 6022
Die Anforderungen an die Luftqualität, die von einer lüftungstechnischen Anlage geliefert wird, und damit auch die Anforderungen an die Anlage selbst, hängen im Wesentlichen von der Nutzung der versorgten Räume ab. Versorgt eine lüftungstechnische Anlage Arbeitsstätten, fällt sie automatisch unter das Arbeitsschutzgesetz und die untergeordneten Regelwerke und muss permanent auf dem Stand der Technik gehalten werden. Dieser entspricht aktuell der VDI 6022, wonach dieses technische Regelwerk auch zwingend umzusetzen ist.
In der Arbeitsstättenverordnung (§ 4) wird zudem verlangt, dass raumlufttechnische Anlagen (RLT-Anlagen) regelmäßig auf ihre Funktion geprüft werden müssen. Sie müssen gesundheitlich verträgliche Luft liefern und betriebssicher funktionieren.
In der VDI 6022 entspricht diese Prüfung der so genannten Hygieneinspektion. Diese ist für RLT-Anlagen in Abständen von 2 Jahren (Anlagen mit Luftbefeuchter) bzw. 3 Jahren (Anlagen ohne Luftbefeuchter) vorzunehmen. Die Anlagenprüfungen müssen durch qualifiziertes Personal durchgeführt werden und bestimmte Mindestanforderungen erfüllen, um im „Ernstfall“ auch rechtssicher zu sein. Die Hygieneinspektion der DMT erfüllt diese Anforderungen. Zum Leistungsspektrum gehören:
Begutachtung der RLT-Gerätekomponenten hinsichtlich
- der Einhaltung konstruktiver Anforderungen der VDI 6022
- Ausführung, Beschädigung und Verschmutzung
- funktionaler Aspekte
Physikalische Klimaparameter (an repräsentativen Messstellen)
- Temperatur
- Relative Luftfeuchte
- CO2-Gehalt
Mikrobiologische Untersuchungen (an repräsentativen Messstellen)
- Keimzahlbestimmung auf Oberflächen von RLT-Gerätekomponenten mittels Abklatschproben
- Keimgehalte in der Zuluft sowie Referenzmessung der Außenluft (Vergleichsluft)
- Bestimmung der Koloniezahl und des Legionellengehaltes im Umlaufwasser und Zuspeisewasser von Luftbefeuchtern
Wenn Ihr Gebäude unter die Technische Prüfverordnung (siehe auch Erstabnahmen und Wiederholungsprüfungen nach PrüfVO) fällt, können unsere Sachverständigen die geforderten Prüfungen auch in Kombination mit der Hygieneinspektion für Sie durchführen. Dadurch ergeben sich für Sie Kostenvorteile.
Unter "Weiterbildung" finden Sie unsere Schulungen zur Raumlufthygiene nach VDI 6022.